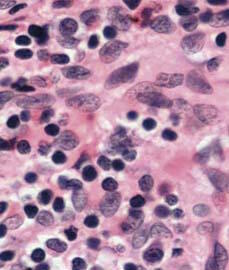

Shatavari : ce que dit la recherche
| Une étude de la littérature classique Ayur-védique attribue à la racine de Shatavari un certain nombre d'effets thérapeutiques : elle a été spécialement recommandée dans des cas de risques d'avortement et comme galactagogue (substance favorisant la sécrétion lactée). Des effets bénéfiques de la racine de Shatavari ont été évoqués sur les troubles nerveux, la dyspepsie, la diarrhée, la dysenterie, des tumeurs, des inflammations, la neuropathie, des pathologies hépatiques, la toux, la bronchite, l'hyperacidité ou certaines maladies infectieuses. La recherche scientifique est loin d'avoir démontré la réalité de tous ces effets mais il existe cependant un certain nombre de travaux scientifiques intéressants. |
| Effet galactagogue
Dans la médecine Ayur-védique, l'extrait de racine de Shatavari est prescrit pour augmenter la sécrétion de lait au cours de l'allaitement. Cet effet a été attribué à une action de libération de corticostéroïdes ou à une augmentation de la prolactine, l'hormone déclenchant la sécrétion lactée après l'accouchement. |
|
On a montré chez des buffles que Shatavari stimule la production de lait1. Cet effet galactagénique a été confirmé par un essai clinique2. Un extrait de Shatavari combiné à d'autres extraits de plantes a augmenté la sécrétion de lait chez des femmes se plaignant de ne pas avoir suffisamment de lait3. Le fait qu'une diminution progressive de la sécrétion lactée se soit produite avec l'arrêt du traitement suggère que l'amélioration obtenue est bien due à la seule supplémentation et non à un quelconque effet psychologique. |
 |
|
L'administration systémique d'un extrait alcoolique de Shatavari chez des rats en cours de sevrage a augmenté le poids des glandes mammaires, inhibant l'involution du tissu lobulo-alvéolaire et maintenant la sécrétion lactée. |
| Activité hormonale
On a montré que des extraits de Shatavari interagissent avec les récepteurs androgènes et peuvent ainsi inhiber la croissance prostatique androgène dépendante. Les saponines stéroïdiennes contenues dans Shatavari pourraient être responsables d'un effet similaire à celui que pourraient avoir des hormones expliquant son utilisation traditionnelle comme tonique de la reproduction. |
 |
| Effets gastro-Intestinaux
De la poudre de racine sèche est utilisée par la médecine Ayur-védique pour traiter la dyspepsie. On a montré, chez des personnes en bonne santé, qu'elle favorise la vidange de l'estomac. Son action est comparable à celle d'un antagoniste synthétique de la dopamine, le métoclopromide4, justifiant son utilisation traditionnelle dans le traitement de la dyspepsie. |
| Activités immuno-modulatrices |
|
Des septicémies intra-abdominales sont des causes importantes de mortalité après un traumatisme ou une opération des intestins. Les propriétés immuno-modulatrices de Shatavari ont montré leur capacité à protéger des rats et des souris contre une septicémie abdominale développée de façon expérimentale6,7. On a ainsi montré que l'administration orale d'une décoction de poudre de Shatavari produit une leucocytose (augmentation passagère du nombre de globules blancs) et des neutrophiles en même temps qu'elle stimule l'activité de phagocytose des macrophages et des polymorphes. Le pourcentage de mortalité chez les animaux traités avec Shatavari était réduit de façon significative avec un taux de survie comparable à celui d'un groupe d'animaux traités par une association de métronidazole et de gentamicine. |
1. Bharatiya Vidya Bhavan's Swami Prakashananda Ayurveda research centre. Selected Medicinal Plants of India. 43-46. 92. Bombay, Chemexcil. 2. Sharma S., Ramji S. et al., Randomized controlled trial of Asparagus racemosus (Shatavari) as a lactogogue in lactational inadequacy. Indian Pediatr. 1996;33:675-7. 3. Joglekar G.V. et al., Galactogogic effect of Asparagus racemosus. Ind Med J. 1967;61:165. 4. Dalvi S.S. et al., Effect of Asparagus racemosus (Shatavari) on gastric emptying time in normal healthy volunteers. J Postgrad Med 1990; 36:91-4. 5. Singh K.P. et al., Clinical trial on Shatavari in duodenal ulcer disease. J Res Ay Sid 1986; 7 91-100. 6. Dahanukar S. et al., Protective effect of Asparagus racemosus against induced abdominal sepsis. Indian Drugs 1986; 24: 125-8) 7. Thatte U. et al., Immunotherapeutic modification of E. coli induced abdominal sepsis and mortality in mice by Indian medicinal plants. Indian Drugs 1987; 25: 95-7. |
Tous droits de reproduction réservés
Gratuit
Merci de votre visite, avant de partir
inscrivez-vous auClub SuperSmart
d'avantages exclusifs:
- Gratuit : la publication hebdomadaire scientifique "Nutranews"
- Des promotions exclusives aux membres du club



 Format PDF
Format PDF













